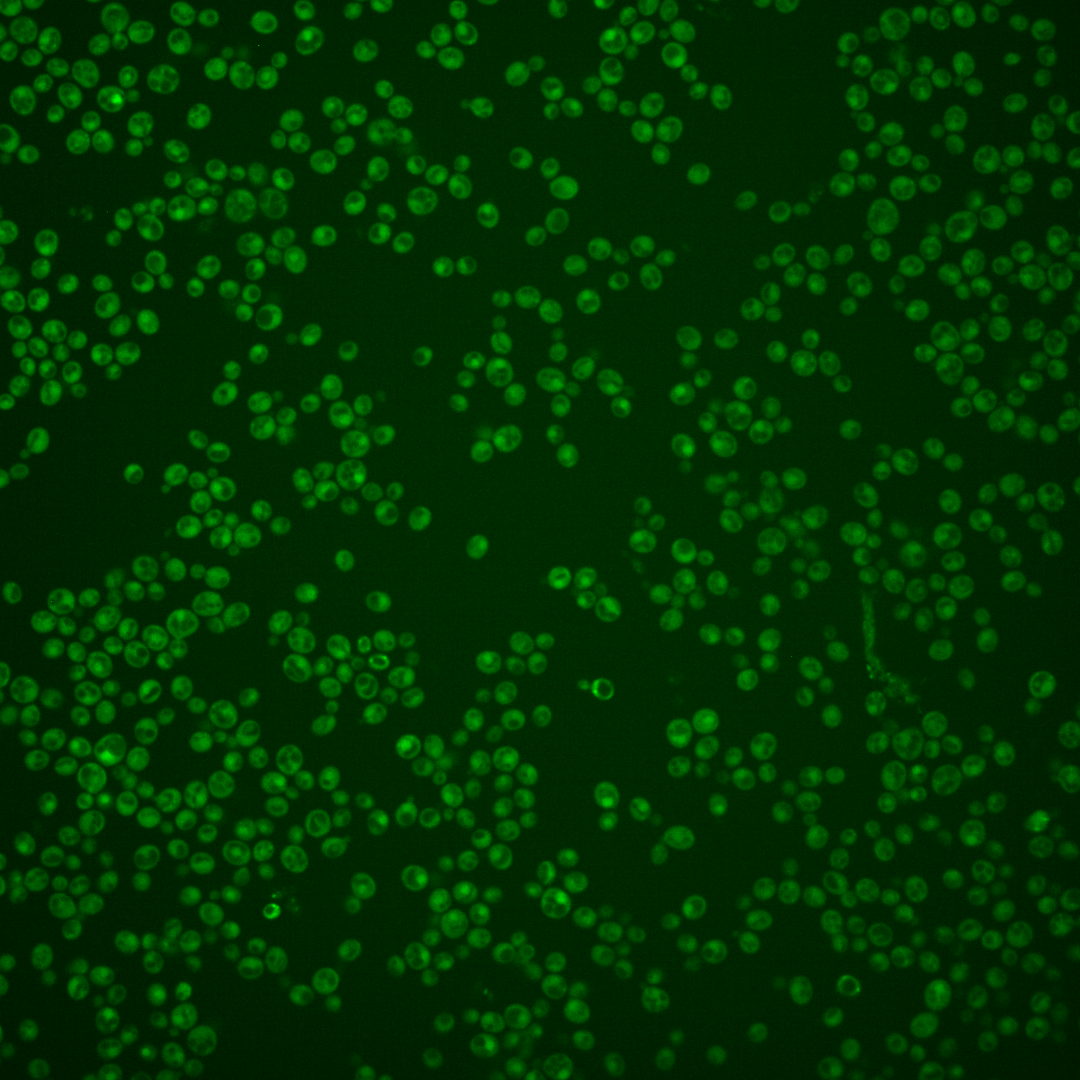
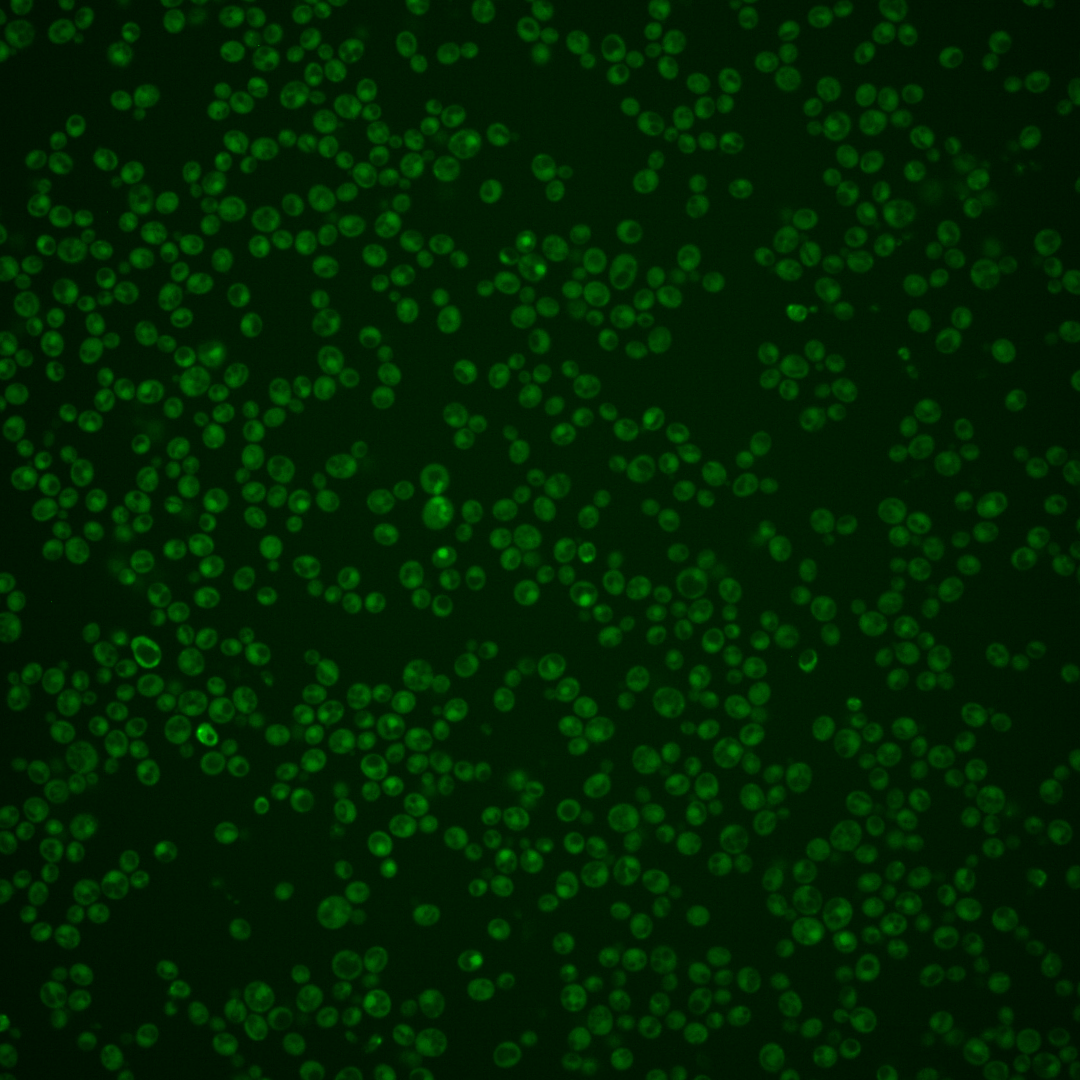
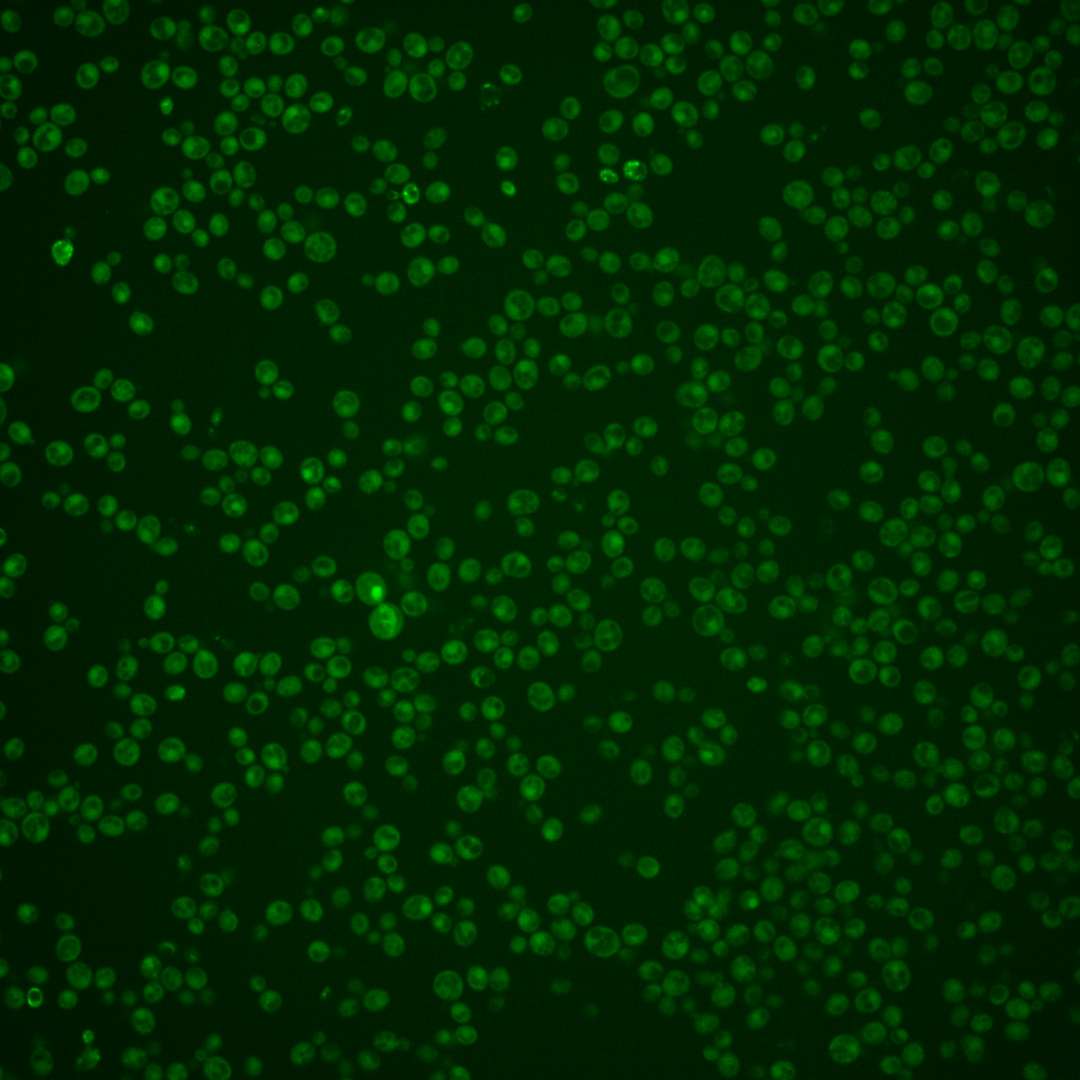

| Standard name | |
|---|---|
| Human Ortholog | |
| Description | Nucleotide excision repair (NER) protein; binds damaged DNA during NER; binds DNA in an ATP-dependent manner (with Rad16p) during NER; required for repair of non-transcribed chromatin; subunit of Nucleotide Excision Repair Factor 4 (NEF4) and the Elongin-Cullin-Socs (ECS) ligase complex |
Micrographs




















































































Sub-cellular Localization
Yeast GFP Assignment
Protein Abundance
Localization Change
External localization resources
| ensLOC | DeepLoc | |||||||||||||||||||||||
|---|---|---|---|---|---|---|---|---|---|---|---|---|---|---|---|---|---|---|---|---|---|---|---|---|
| Localization | WT1 | WT2 | WT3 | RAP60 | RAP140 | RAP220 | RAP300 | RAP380 | RAP460 | RAP540 | RAP620 | RAP700 | HU80 | HU120 | HU160 | rpd3Δ_1 | rpd3Δ_2 | rpd3Δ_3 | WT1 | WT2 | WT3 | AF100 | AF140 | AF180 |
| Cortical Patches | 0 | 0 | 1 | 0 | 0 | 0 | 0 | – | 0 | 0 | 0 | 0 | 0 | 0 | 0 | 1 | 0 | 0 | 1 | 2 | 1 | 0 | 0 | 1 |
| Bud | 2 | 0 | 0 | 0 | 0 | 1 | 0 | – | 3 | 3 | 5 | 4 | 1 | 0 | 0 | 0 | 1 | 1 | 0 | 0 | 1 | 0 | 0 | 3 |
| Bud Neck | 1 | 0 | 10 | 4 | 2 | 1 | 7 | – | 3 | 3 | 1 | 4 | 0 | 0 | 1 | 0 | 0 | 0 | 0 | 1 | 1 | 0 | 0 | 1 |
| Bud Site | 0 | 0 | 0 | 0 | 0 | 1 | 0 | – | 10 | 7 | 10 | 7 | 0 | 0 | 0 | 0 | 0 | 0 | – | – | – | – | – | – |
| Cell Periphery | 3 | 0 | 1 | 2 | 0 | 0 | 1 | – | 1 | 0 | 0 | 0 | 0 | 0 | 0 | 0 | 0 | 0 | 1 | 0 | 1 | 0 | 0 | 0 |
| Cytoplasm | 128 | 41 | 185 | 230 | 180 | 194 | 150 | – | 99 | 87 | 103 | 110 | 113 | 117 | 126 | 14 | 6 | 10 | 112 | 42 | 115 | 27 | 48 | 79 |
| Endoplasmic Reticulum | 0 | 0 | 0 | 1 | 0 | 0 | 0 | – | 0 | 0 | 0 | 0 | 2 | 0 | 1 | 5 | 3 | 4 | 7 | 0 | 2 | 0 | 0 | 0 |
| Endosome | 5 | 0 | 1 | 0 | 1 | 0 | 0 | – | 3 | 3 | 1 | 0 | 0 | 1 | 0 | 2 | 5 | 0 | 2 | 1 | 1 | 0 | 0 | 1 |
| Golgi | 0 | 0 | 0 | 0 | 0 | 0 | 0 | – | 0 | 0 | 0 | 0 | 0 | 0 | 0 | 1 | 0 | 2 | 1 | 0 | 0 | 0 | 0 | 0 |
| Mitochondria | 26 | 1 | 0 | 4 | 3 | 44 | 63 | – | 111 | 83 | 200 | 105 | 0 | 0 | 1 | 12 | 14 | 5 | 31 | 11 | 31 | 0 | 1 | 4 |
| Nucleus | 27 | 15 | 27 | 34 | 60 | 123 | 142 | – | 181 | 170 | 217 | 230 | 19 | 20 | 30 | 211 | 191 | 180 | 35 | 21 | 31 | 4 | 20 | 14 |
| Nuclear Periphery | 3 | 0 | 0 | 0 | 0 | 0 | 0 | – | 2 | 0 | 3 | 1 | 0 | 0 | 0 | 0 | 0 | 0 | 0 | 0 | 0 | 0 | 0 | 0 |
| Nucleolus | 1 | 0 | 0 | 0 | 1 | 0 | 2 | – | 9 | 7 | 24 | 12 | 0 | 0 | 0 | 3 | 4 | 0 | 0 | 0 | 0 | 0 | 0 | 1 |
| Peroxisomes | 0 | 0 | 0 | 0 | 0 | 0 | 0 | – | 0 | 0 | 0 | 0 | 0 | 0 | 0 | 0 | 0 | 0 | 0 | 0 | 0 | 0 | 0 | 0 |
| SpindlePole | 2 | 0 | 1 | 1 | 4 | 0 | 7 | – | 5 | 10 | 3 | 13 | 0 | 0 | 2 | 2 | 2 | 0 | 5 | 1 | 2 | 2 | 2 | 4 |
| Vac/Vac Membrane | 14 | 2 | 4 | 4 | 17 | 24 | 11 | – | 5 | 6 | 10 | 8 | 1 | 5 | 3 | 13 | 11 | 13 | 25 | 12 | 25 | 3 | 10 | 11 |
| Unique Cell Count | 185 | 57 | 218 | 268 | 260 | 356 | 338 | 352 | 317 | 426 | 413 | 135 | 140 | 159 | 244 | 216 | 200 | 231 | 98 | 228 | 41 | 91 | 129 | |
| Labelled Cell Count | 212 | 59 | 230 | 280 | 268 | 388 | 383 | 432 | 379 | 577 | 494 | 136 | 143 | 164 | 264 | 237 | 215 | 231 | 98 | 228 | 41 | 91 | 129 | |
Yeast GFP Assignment
Protein Abundance
| Screen | WT1 | WT2 | WT3 | RAP60 | RAP140 | RAP220 | RAP300 | RAP380 | RAP460 | RAP540 | RAP620 | RAP700 | HU80 | HU120 | HU160 | rpd3Δ_1 | rpd3Δ_2 | rpd3Δ_3 | AF100 | AF140 | AF180 |
|---|---|---|---|---|---|---|---|---|---|---|---|---|---|---|---|---|---|---|---|---|---|
| Mean Cell GFP Intensity (1e-4) | 3.5 | 5.0 | 5.1 | 4.7 | 5.3 | 4.3 | 4.4 | – | 4.2 | 4.4 | 3.9 | 4.2 | 5.1 | 5.3 | 5.3 | 8.0 | 7.6 | 7.2 | – | 4.8 | 5.5 |
| Std Deviation (1e-4) | 0.6 | 1.3 | 1.0 | 1.4 | 1.4 | 0.9 | 1.3 | – | 1.0 | 1.2 | 1.3 | 1.2 | 1.7 | 1.3 | 1.5 | 1.6 | 1.5 | 1.5 | – | 1.3 | 1.9 |
| Intensity Change (Log2) | – | – | – | -0.1 | 0.05 | -0.25 | -0.19 | – | -0.27 | -0.21 | -0.37 | -0.26 | 0.02 | 0.06 | 0.05 | 0.65 | 0.59 | 0.51 | – | -0.08 | 0.11 |
Localization Change
| Localization | RAP60 | RAP140 | RAP220 | RAP300 | RAP380 | RAP460 | RAP540 | RAP620 | RAP700 | HU80 | HU120 | HU160 | rpd3Δ_1 | rpd3Δ_2 | rpd3Δ_3 |
|---|---|---|---|---|---|---|---|---|---|---|---|---|---|---|---|
| Cortical Patches | 0 | 0 | 0 | 0 | – | 0 | 0 | 0 | 0 | 0 | 0 | 0 | 0 | 0 | 0 |
| Bud | 0 | 0 | 0 | 0 | – | 0 | 0 | 0 | 0 | 0 | 0 | 0 | 0 | 0 | 0 |
| Bud Neck | 0 | -2.7 | 0 | 0 | – | 0 | 0 | 0 | 0 | 0 | 0 | 0 | 0 | 0 | 0 |
| Bud Site | 0 | 0 | 0 | 0 | – | 0 | 0 | 0 | 0 | 0 | 0 | 0 | 0 | 0 | 0 |
| Cell Periphery | 0 | 0 | 0 | 0 | – | 0 | 0 | 0 | 0 | 0 | 0 | 0 | 0 | 0 | 0 |
| Cytoplasm | 0.3 | -4.0 | -7.5 | -9.5 | – | -13.2 | -13.1 | -14.7 | -13.9 | -0.3 | -0.3 | -1.4 | -17.1 | -17.2 | -16.3 |
| Endoplasmic Reticulum | 0 | 0 | 0 | 0 | – | 0 | 0 | 0 | 0 | 0 | 0 | 0 | 0 | 0 | 0 |
| Endosome | 0 | 0 | 0 | 0 | – | 0 | 0 | 0 | 0 | 0 | 0 | 0 | 0 | 0 | 0 |
| Golgi | 0 | 0 | 0 | 0 | – | 0 | 0 | 0 | 0 | 0 | 0 | 0 | 0 | 0 | 0 |
| Mitochondria | 0 | 0 | 0 | 0 | – | 0 | 0 | 0 | 0 | 0 | 0 | 0 | 3.3 | 3.8 | 0 |
| Nucleus | 0.1 | 3.0 | 5.9 | 7.4 | – | 9.4 | 9.7 | 9.5 | 10.5 | 0.5 | 0.5 | 1.7 | 15.9 | 15.8 | 15.9 |
| Nuclear Periphery | 0 | 0 | 0 | 0 | – | 0 | 0 | 0 | 0 | 0 | 0 | 0 | 0 | 0 | 0 |
| Nucleolus | 0 | 0 | 0 | 0 | – | 0 | 0 | 0 | 0 | 0 | 0 | 0 | 0 | 0 | 0 |
| Peroxisomes | 0 | 0 | 0 | 0 | – | 0 | 0 | 0 | 0 | 0 | 0 | 0 | 0 | 0 | 0 |
| SpindlePole | 0 | 0 | 0 | 0 | – | 0 | 0 | 0 | 0 | 0 | 0 | 0 | 0 | 0 | 0 |
| Vacuole | 0 | 2.5 | 2.6 | 1.0 | – | 0 | 0 | 0 | 0 | 0 | 0 | 0 | 2.0 | 1.9 | 2.4 |
External localization resources
Images






























Protein Concentration and Protein Localization Data
| R1 | R2 | R3 | ||||||||||||||||
|---|---|---|---|---|---|---|---|---|---|---|---|---|---|---|---|---|---|---|
| G1 Pre-START | G1 Post-START | S/G2 | Metaphase | Anaphase | Telophase | G1 Pre-START | G1 Post-START | S/G2 | Metaphase | Anaphase | Telophase | G1 Pre-START | G1 Post-START | S/G2 | Metaphase | Anaphase | Telophase | |
| Concentration | -0.5694 | -0.9179 | -0.7958 | -0.9099 | -1.2764 | -0.7836 | -0.9765 | -0.5805 | -0.9215 | -0.9372 | -1.3287 | -0.9759 | -0.2467 | -0.9938 | -0.8097 | -1.1097 | -0.7618 | -1.0241 |
| Actin | 0.0473 | 0.0002 | 0.0016 | 0.0016 | 0.0007 | 0.0015 | 0.0131 | 0.0001 | 0.0131 | 0.0008 | 0.0011 | 0.0007 | 0.0542 | 0.002 | 0.0088 | 0.0319 | 0.1215 | 0.0005 |
| Bud | 0.0007 | 0.0023 | 0.0002 | 0.0001 | 0.0019 | 0.0001 | 0.0012 | 0.0004 | 0.0009 | 0.0027 | 0.0001 | 0.0013 | 0.003 | 0.001 | 0.0007 | 0.0117 | 0.001 | 0.0002 |
| Bud Neck | 0.0056 | 0.0004 | 0.0002 | 0.0002 | 0.0009 | 0.0016 | 0.0005 | 0.0008 | 0.0006 | 0.0014 | 0.0003 | 0.0011 | 0.0088 | 0.0003 | 0.0009 | 0.0019 | 0.0005 | 0.0011 |
| Bud Periphery | 0.0016 | 0.0037 | 0.0003 | 0.0001 | 0.0013 | 0.0002 | 0.001 | 0.0002 | 0.0025 | 0.0023 | 0.0001 | 0.0052 | 0.0061 | 0.0029 | 0.0008 | 0.0062 | 0.0019 | 0.0002 |
| Bud Site | 0.003 | 0.0061 | 0.0022 | 0.0001 | 0.0006 | 0.0002 | 0.0043 | 0.0087 | 0.0014 | 0.0332 | 0.0001 | 0.0005 | 0.0112 | 0.0203 | 0.013 | 0.0037 | 0.0014 | 0.0001 |
| Cell Periphery | 0.0002 | 0.0001 | 0 | 0 | 0.0001 | 0 | 0.0003 | 0.0002 | 0.0001 | 0.0003 | 0 | 0.0001 | 0.0009 | 0.0002 | 0.0003 | 0.0004 | 0.0002 | 0 |
| Cytoplasm | 0.0414 | 0.0435 | 0.0393 | 0.0339 | 0.0498 | 0.0671 | 0.0235 | 0.0174 | 0.044 | 0.0379 | 0.029 | 0.055 | 0.0417 | 0.067 | 0.0491 | 0.061 | 0.0431 | 0.1167 |
| Cytoplasmic Foci | 0.0196 | 0.0105 | 0.004 | 0.0144 | 0.0093 | 0.0148 | 0.0117 | 0.0095 | 0.0099 | 0.0288 | 0.0026 | 0.0072 | 0.0421 | 0.0046 | 0.0133 | 0.0175 | 0.0112 | 0.0172 |
| Eisosomes | 0.0009 | 0.0001 | 0.0002 | 0.0001 | 0.0001 | 0.0001 | 0.0004 | 0.0001 | 0.0002 | 0.0001 | 0.0002 | 0.0001 | 0.0006 | 0.0002 | 0.0002 | 0.0004 | 0.0005 | 0.0001 |
| Endoplasmic Reticulum | 0.0038 | 0.0011 | 0.0011 | 0.0008 | 0.0028 | 0.0015 | 0.0025 | 0.0003 | 0.0018 | 0.0008 | 0.0004 | 0.0004 | 0.0052 | 0.0007 | 0.0013 | 0.0025 | 0.0026 | 0.001 |
| Endosome | 0.0097 | 0.0011 | 0.001 | 0.0184 | 0.0029 | 0.0021 | 0.0215 | 0.0008 | 0.0166 | 0.0056 | 0.0024 | 0.0055 | 0.0302 | 0.0007 | 0.0115 | 0.0091 | 0.0066 | 0.003 |
| Golgi | 0.0052 | 0.0001 | 0.0001 | 0.0004 | 0.0002 | 0.0002 | 0.0063 | 0.0003 | 0.0055 | 0.0024 | 0.002 | 0.0007 | 0.0093 | 0.0002 | 0.0048 | 0.006 | 0.0177 | 0.0002 |
| Lipid Particles | 0.0092 | 0.0007 | 0.0004 | 0.0016 | 0.0006 | 0.0006 | 0.0067 | 0.0063 | 0.0037 | 0.0102 | 0.0045 | 0.0093 | 0.0308 | 0.0003 | 0.0046 | 0.0082 | 0.0568 | 0.0007 |
| Mitochondria | 0.0021 | 0.0006 | 0.0004 | 0.0005 | 0.0013 | 0.0005 | 0.0352 | 0.0004 | 0.0016 | 0.002 | 0.0788 | 0.0015 | 0.0148 | 0.0009 | 0.0109 | 0.0107 | 0.012 | 0.0006 |
| None | 0.6718 | 0.8021 | 0.8318 | 0.7207 | 0.7252 | 0.7657 | 0.7534 | 0.8222 | 0.7514 | 0.6282 | 0.6707 | 0.7536 | 0.5437 | 0.8124 | 0.7393 | 0.7393 | 0.5709 | 0.6433 |
| Nuclear Periphery | 0.0093 | 0.0038 | 0.0022 | 0.0048 | 0.0119 | 0.0041 | 0.0101 | 0.0016 | 0.0027 | 0.0026 | 0.0022 | 0.0011 | 0.0126 | 0.0008 | 0.0034 | 0.0083 | 0.0018 | 0.0027 |
| Nucleolus | 0.0021 | 0.0029 | 0.0015 | 0.003 | 0.0047 | 0.0021 | 0.0038 | 0.0057 | 0.0034 | 0.0049 | 0.0033 | 0.0027 | 0.0053 | 0.0007 | 0.0016 | 0.0039 | 0.0044 | 0.0022 |
| Nucleus | 0.112 | 0.1048 | 0.0976 | 0.1726 | 0.1389 | 0.1233 | 0.0876 | 0.1049 | 0.1208 | 0.2021 | 0.1829 | 0.1342 | 0.1238 | 0.0803 | 0.1064 | 0.0589 | 0.1019 | 0.1848 |
| Peroxisomes | 0.0099 | 0.0005 | 0.0003 | 0.0033 | 0.0004 | 0.0011 | 0.0055 | 0.0005 | 0.005 | 0.0108 | 0.0056 | 0.0013 | 0.0346 | 0.0012 | 0.013 | 0.007 | 0.0397 | 0.0008 |
| Punctate Nuclear | 0.0425 | 0.0145 | 0.0149 | 0.0199 | 0.0432 | 0.0122 | 0.0085 | 0.0188 | 0.0138 | 0.0184 | 0.0134 | 0.0165 | 0.0105 | 0.0024 | 0.0122 | 0.0063 | 0.0025 | 0.0225 |
| Vacuole | 0.0015 | 0.0008 | 0.0004 | 0.0027 | 0.0026 | 0.0007 | 0.0017 | 0.0008 | 0.001 | 0.0041 | 0.0002 | 0.0018 | 0.008 | 0.0011 | 0.0036 | 0.0038 | 0.0013 | 0.0016 |
| Vacuole Periphery | 0.0006 | 0.0002 | 0.0001 | 0.0007 | 0.0007 | 0.0002 | 0.0012 | 0.0001 | 0.0002 | 0.0005 | 0.0002 | 0.0002 | 0.0026 | 0.0001 | 0.0003 | 0.0013 | 0.0005 | 0.0003 |
Sequencing Data
| R1 | R2 | |||||||||
|---|---|---|---|---|---|---|---|---|---|---|
| G1 Post-START | S/G2 | Metaphase | Anaphase | Telophase | G1 Post-START | S/G2 | Metaphase | Anaphase | Telophase | |
| Gene Expression | 7.473 | 5.809 | 6.0348 | 9.808 | 7.5827 | 5.8452 | 9.6913 | 10.9016 | 11.0707 | 10.8481 |
| Translational Efficiency | 1.0364 | 1.6624 | 1.2989 | 0.9118 | 1.2055 | 2.0837 | 1.1621 | 1.0087 | 1.0473 | 1.0746 |
Hit Data
| Dataset | Hit |
|---|---|
| Protein Concentration | ✘ |
| Protein Localization | ✘ |
| Gene Expression | ✘ |
| Translational Efficiency | ✘ |
Endocytosis
| Temp | Actin Patch (Sac6-tdTomato) | Cortical Patch (Sla1-GFP) | Late Endosome (Snf7-GFP) | Vacuole (Vph1-GFP) |
|---|---|---|---|---|
| 37℃ | ||||
| RT |
Cell Cycle Omics
CYCLoPs (Rad7-GFP)
| Gene / Allele | Actin Patch (Sac6-tdTomato) | Cortical Patch (Sla1-GFP) | Late Endosome (Snf7-GFP) | Vacuole (Sac6-tdTomato) |
|---|
| Gene | Images |
|---|
| Gene | Images |
|---|
Images are not yet available
Images are not yet available